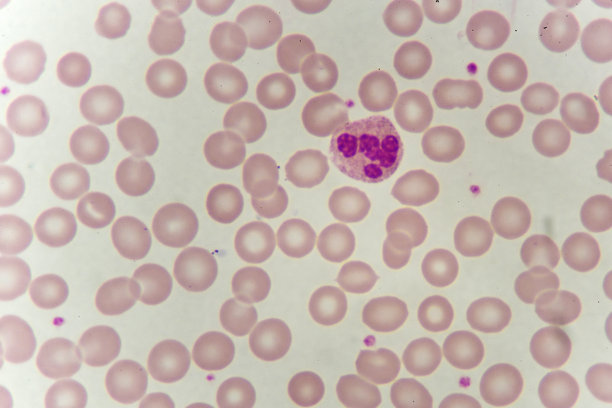

嗜中性粒细胞

请先登录后再下载
58明星,嗜中性粒细胞,嗜曙红细胞,嗜碱细胞,吞噬细胞,噬菌作用,抗原,白细胞,细胞核,免疫系统,骨髓膜,细胞质,血液学,粒子,微生物学,细胞,人体细胞,微生物,生物学,血液,动物血液,绘画插图,三维图形,生病,方形画幅,白色背景,花瓣,健康保健,人,图像,摄影